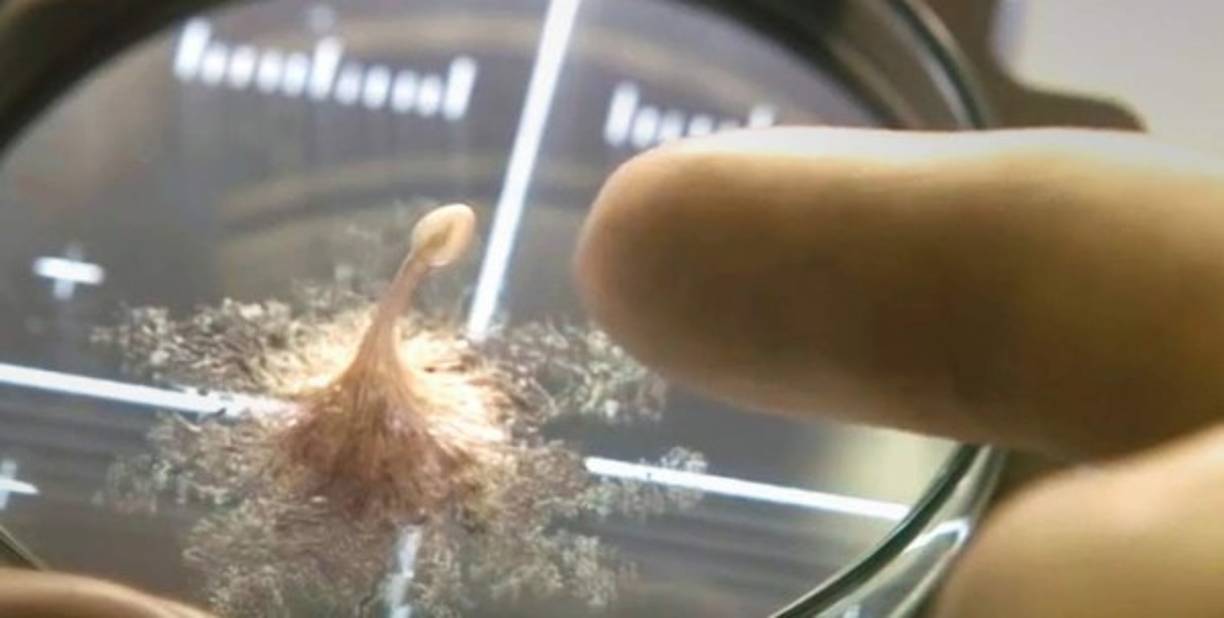
'He escuchado de algunos colegas en el área de vuelos espaciales humanos que pueden ver cómo, en el entorno actual, la ciudadanía podría volverse más preocupada por la llegada de algún microbio, virus o contaminación extraterrestre', dijo.

Últimas Fotogalerías
Alerta: Virus extraterrestres pueden llegar en cualquier momento advierte excolaborador de la NASA
El excolaborador de la NASA, Scott Hubbard, advirtió que los virus extraterrestres pueden llegar a la Tierra.
- Actualizado: 15 mayo 2020 /
-
 1 / 6Todavía los científicos no han encontrado la cura para el COVID-19 y ya se deben preparar para una nueva amenenaza: los virus extraterrestres.
1 / 6Todavía los científicos no han encontrado la cura para el COVID-19 y ya se deben preparar para una nueva amenenaza: los virus extraterrestres. -
 2 / 6En una entrevista publicada por Stanford News, el excolaborador de la NASA, Scott Hubbard, habló de la llegada de virus a la Tierra desde el Espacio, producto de las misiones espaciales.
2 / 6En una entrevista publicada por Stanford News, el excolaborador de la NASA, Scott Hubbard, habló de la llegada de virus a la Tierra desde el Espacio, producto de las misiones espaciales. -
 3 / 6El investigador sugiere que los astronautas y las muestras de rocas procedentes de Marte u otros cuerpos celestes en futuras misiones espaciales deberán verificarse y ponerse en cuarentena para evitar el ingreso de los virus.
3 / 6El investigador sugiere que los astronautas y las muestras de rocas procedentes de Marte u otros cuerpos celestes en futuras misiones espaciales deberán verificarse y ponerse en cuarentena para evitar el ingreso de los virus. -
 4 / 6'He escuchado de algunos colegas en el área de vuelos espaciales humanos que pueden ver cómo, en el entorno actual, la ciudadanía podría volverse más preocupada por la llegada de algún microbio, virus o contaminación extraterrestre', dijo.
4 / 6'He escuchado de algunos colegas en el área de vuelos espaciales humanos que pueden ver cómo, en el entorno actual, la ciudadanía podría volverse más preocupada por la llegada de algún microbio, virus o contaminación extraterrestre', dijo. -
 5 / 6El experto asegura que todavía no hay evidencia de que exista en la Tierra un virus del espacio, pero advierte que estos pueden ser muchos más mortales que los que conocemos actualmente.
5 / 6El experto asegura que todavía no hay evidencia de que exista en la Tierra un virus del espacio, pero advierte que estos pueden ser muchos más mortales que los que conocemos actualmente. -
 6 / 6Hubbard sostiene que de ahora en adelante es indispensable poner las muestras extraídas de otros planetas y tratarlas 'como si fueran el virus del Ébola hasta que se demuestre que son seguras', así mismo sugiere que los astronautas sean también puestos en cuarentena.
6 / 6Hubbard sostiene que de ahora en adelante es indispensable poner las muestras extraídas de otros planetas y tratarlas 'como si fueran el virus del Ébola hasta que se demuestre que son seguras', así mismo sugiere que los astronautas sean también puestos en cuarentena.